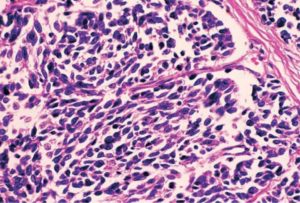
image

Среди всех злокачественных новообразований легкого на долю мелкоклеточного рака приходится около 15%.
Тем не менее, эта форма отличается высокой агрессивностью, быстрым течением и далеко не всегда поддается лечению.
Поэтому врачи и ученые активно изучают данное заболевание, разрабатывают новые методы диагностики и создают современные препараты, которые помогли бы улучшить показатели выживаемости.
Морфологически этот вид рака характеризуется образованием опухолевых клеток небольшого размера, большую часть которых занимает ядро. По одной теории, их предшественниками являются клетки эпителия бронхов, которые имеют схожее строение. Другая теория рассматривает в качестве предшественников APUD-клетки, которые являются составной частью диффузной эндокринной системы легкого.
Чаще всего заболевание выявляется у курящих мужчин, возраст которых составляет от 40 до 60 лет.
Именно этим двум факторам (связь с курением и возраст) отводится главная роль в структуре причин возникновения мелкоклеточного рака легкого.
В последние десятилетия отмечается увеличение числа курящих женщин, поэтому их доля в структуре заболеваемости постепенно увеличивается. Среди других факторов, которые могут способствовать развитию мелкоклеточного рака отмечаются:
- Неблагоприятная экологическая обстановка.
- Работа во вредных условиях труда.
- Отягощенный наследственный анамнез (выявление у близких родственников рака легкого или других онкологических заболеваний).
- Влияние на организм ионизирующего излучения.
- Сопутствующие заболевания легких (туберкулез, ХОБЛ).
Чем больше на человека воздействует неблагоприятных факторов, тем выше риск развития рака легкого.
Симптомы заболевания
У большинства пациентов на начальных стадиях рака какие-либо клинические проявления отсутствуют. У курильщиков может отмечаться продолжительный кашель, который они связывают с бронхитом и другими последствиями этой пагубной привычки.
Другим характерным симптомом является появление крови в мокроте. Именно в этот момент пациент должен насторожиться и как можно скорее обратиться к врачу.
Дополнительно могут отмечаться боли в области грудной клетки, одышка, слабость, быстрая утомляемость и др.
Симптомы рака легких на более поздних стадиях обусловлены распространением процесса на соседние органы и ткани. В таких случаях могут отмечаться следующие проявления:
- Осиплость голоса.
- Дисфагия (нарушение глотания).
- Сдавление верхней полой вены.
- Синдром Кушинга и др.
При распространении (метастазировании) мелкоклеточного рака в другие органы, развиваются специфические симптомы, например, желтуха. Могут возникать неврологические нарушения, боль в позвоночнике и т. д.
Классификация болезни проводится по нескольким параметрам. Как и для других видов рака, актуальной является TNM-классификация, которая учитывает особенности роста опухоли и ее распространение по организму. Буква Т описывает первичный опухолевый очаг в следующих вариантах:
- Х — раковые клетки не обнаружены или недостаточно данных для оценки мелкоклеточного рака.
- 0 — первичный очаг не выявлен.
- Is (рак in situ) — рак легкого не распространяется на соседние ткани и ограничен небольшой группой клеток.
- 1 — размер опухоли легкого не превышает 3 см, и она не переходит на главный бронх.
- 2 — размер опухоли более 3 см, она не распространяется на все легкое.
- 3 — опухоль может иметь любой размер и распространяться на диафрагму, плевру, перикард и др.
- 4 — В этом случае первичный очаг мелкоклеточного рака легкого поражает средостение, сердце, пищевод и другие жизненно важные органы.
N описывает состояние регионарных лимфоузлов. Если недостаточно объективных данных для изучения их состояния, то присваивается индекс «Х», если признаков распространения рака легкого не обнаружено, то присваивается индекс «0». В остальных случаях, в зависимости от объема поражения и распространения процесса, присваивается индекс от 1 до 3.
М описывает процесс метастазирования рака легкого. Как и в предыдущих случаях, индекс «Х» и «0» ставятся тогда, когда недостаточно данных для выявления метастазов или они не обнаружены. При наличии метастазов рака в отдаленных органах и тканях, ставится индекс «1».
Если они не выходят за пределы грудной клетки, то индекс меняется на «1а», а если выходят за пределы грудной клетки, то он изменяется на «1b».
Таким образом, диагноз Т2N1M0 можно интерпретировать следующим образом: мелкоклеточный рак легкого, размер первичного очага более 3 см, который прорастает плевру, но не поражает все легкое, с поражением регионарных лимфоузлов, без признаков отдаленных метастазов.
По совокупности показателей T, N, и M, мелкоклеточный рак легкого делится на 4 стадии. На первой — размер опухоли не превышает 3 см, она локализована в пределах одного сегмента, метастазы (регионарные и отдаленные) не выявляются.
Для второй стадии рака характерны размеры до 6 см и могут быть единичные метастазы в близлежащих лимфоузлах (N0-1). На третьей стадии опухоль превышает 6 см и характеризуется инвазивным ростом — переходит на соседние доли, поражает главный бронх и может давать метастазы в отдаленные лимфоузлы.
Четвертая стадия заболевания характеризуется распространением за границы грудной клетки с множественными отдаленными метастазами и тяжелыми осложнениями.
Гистологическая классификация мелкоклеточного рака подразумевает его деление на овсяноклеточный, веретеноклеточный и плеоморфный, в зависимости от клеточного строения опухоли.
Методы диагностики
Для того, чтобы установить точный диагноз, определить стадию мелкоклеточного рака и подобрать лечение, назначается комплексная диагностика. На первом этапе необходимо выявить опухоль, установить ее точную локализацию, размеры, особенности роста. С этой целью назначают лучевую диагностику (рентген и КТ грудной клетки), МРТ легких, ПЭТ-КТ и т. д.
Далее врач должен подтвердить диагноз мелкоклеточного рака морфологически. Для этого необходимо взять образец ткани и исследовать его под микроскопом. Получить материал позволяют следующие методы:
- Биопсия легкого при диагностической торакоскопии.
- Бронхоскопия с биопсией.
- Биопсия лимфоузла.
- Плевральная пункция с забором экссудата.
После выполнения данных исследований можно подтвердить или опровергнуть диагноз мелкоклеточного рака. Однако для того, чтобы узнать, насколько распространен опухолевый процесс, может потребоваться пройти дополнительную диагностику. В частности, выявить наличие метастазов могут помочь такие методы, как сцинтиграфия костей, МРТ головного мозга, МСКТ брюшной полости и др.
В комплексный план диагностики мелкоклеточного рака обязательно включаются лабораторные методы — общий и биохимический анализ крови, анализ мочи, определение уровня онкомаркеров и т. д.
Эти исследования помогут получить дополнительную информацию о состоянии здоровья пациента, отследить динамику изменений после лечения, а также своевременно выявлять осложнения рака.
Точный план обследования всегда составляется индивидуально для каждого пациента.
Тактика лечения во многом зависит от установленного диагноза. Хирургическому лечению поддаются лишь ранние стадии мелкоклеточного рака. При этом оперативное вмешательство обязательно дополняется послеоперационной полихимиотерапией или лучевой терапией. В таком случае можно добиться увеличения показателей выживаемости.
Отличительной особенностью мелкоклеточного рака легкого является высокая вероятность метастазирования, поэтому достаточно эффективным вариантом лечения оказывается химиотерапия. При этом, редко назначается одно лекарственное средство.
Наиболее распространены схемы лечения рака, в которых применяют препараты на основе платины в сочетании с ингибиторами топоизомеразы II. Такой вид лечения позволяет подавить деление клеток мелкоклеточного рака и остановить прогрессирование заболевания.
Химиотерапия назначается курсами (до 6–7) с интервалом между ними около месяца.
Одним из активно развивающихся направлений является таргетная терапия. Она подразумевает применение моноклональных антител, которые «заставляют» иммунную систему атаковать клетки рака легкого.
Среди других методик могут применяться фотодинамическая терапия, лучевая терапия и др. Лечение мелкоклеточного рака легкого может выполняться и с паллиативной целью.
В этом случае речь идет об улучшении качества жизни пациента.
Прогноз и продолжительность жизни
Как и при других видах рака, у пациентов со злокачественными новообразованиями легкого оценивают пятилетнюю выживаемость. Этот показатель зависит от многих факторов — особенностей опухоли, вида лечения, возраста пациента и др. Например, при удалении опухоли на ранней стадии с последующим применением полихимиотерапии, показатель пятилетней выживаемости составляет около 40%.
Если мелкоклеточный рак легкого был диагностирован на более поздних стадиях, то комбинированное лечение позволяет продлить жизнь пациенту на 1.5–2 года. В самых сложных и запущенных случаях, когда рак легкого быстро метастазирует и не поддается лечению, выживаемость не превышает нескольких месяцев.
Записьна консультациюкруглосуточно+7 (495) 151-14-538 800 100 14 98

Спровоцировать мелкоклеточный рак легкого может воздействие на организм различных канцерогенных факторов, основными из которых являются курение и длительный контакт с асбестом. При этом у пациента появляется кашель, кровохаркание и нарушается общее самочувствие.
Лечение зависит от стадии патологии, если рак со вторичными очагами, то показана паллиативная терапия, что направлена на улучшение качества жизни больного.
В случае локальной формы возможно оперативное вмешательство с полным удалением раковой опухоли и выздоровлением пациента.
4 стадия рака легких характеризуется обширными метастазами и онкопациенты живут не более года.
Причины развития
Мелкоклеточная карцинома легкого возникает в результате воздействия на человека таких факторов:
- табакокурение;
- хронические воспалительные заболевания легочной ткани;
- наследственная предрасположенность;
- контакт с пылью на производстве;
- асбестоз;
- недостаточность иммунной противоопухолевой защиты;
- ионизирующее облучение.
Возникает рак легкого в результате воздействия одного или нескольких вредных факторов на организм человека. Заболевание чаще развивается у мужчин возрастом старше 50 лет.
Основной провокатор — стаж курильщика: чем он больше, тем вероятность заболеть злокачественным новообразованием легких возрастает.
В результате формируется очаг атипичных клеток, которые очень быстро растут и размножаются, замещая здоровую легочную ткань. Чем примитивнее клеточные элементы, тем злокачественнее протекает рак.
Разновидности
Мелкоклеточный рак классифицируют в зависимости от форм и строения злокачественных клеток.
По морфологическому строению существуют такие виды мелкоклеточного рака легких:
- овсяноклеточный с преобладанием веретеноподобных клеток;
- смешанный имеет в своем составе плоскоклеточные и овсяноклеточные элементы;
- промежуточный — клетки разных форм.
Мелкоклеточная карцинома имеет неблагоприятный прогноз, так как дает ранние и распространенные метастазы. В зависимости от места расположения опухоли можно выделить такие формы новообразования:
- Центральный рак. Новообразование растет в просвет бронхов и находится за сердцем. Поэтому на рентгенограмме выявить его невозможно. Характерна выраженная симптоматика с болью за грудиной и кровохарканием.
- Периферический. Образуется в бронхиолах и длительное время протекает бессимптомно, но хорошо виден на рентгене, где определяются:
- прорастающая форма, что распространяется на расположенные поблизости сосуды и нервы;
- полостная — с очагом распада в центре.
- Пневмониеподобный рак. Клиника схожа с воспалением легочной ткани.
- Атипичная форма. Обусловлена формированием вторичных очагов. Первоначальная опухоль имеет незначительные размеры и провоцирует развитие симптомов. Существуют такие типы новообразования в зависимости от локализации метастазов:
- костная, которая поражает позвоночник и таз;
- мозговая с клиникой инсульта;
- печеночная, что связана с поражением печени и нарушением оттока желчи.
Основные симптомы
Проявление таких симптомов, как длительный кашель и кровохарканье, указывают на развитие онкологии легких.
Мелкоклеточная форма рака легкого провоцирует развитие у пациента таких характерных клинических признаков:
- длительный кашель;
- кровохаркание;
- нарушение аппетита;
- давление в груди;
- одышка;
- изменение голоса.
Нарастание симптоматики происходит со временем. Вначале заболевание протекает без проявлений. После формирования метастазов возможно появление болей в костях, желтушности кожи и неврологических проявлений, что связаны со вторичными очагами в различных органах. Чаще всего метастазы поражают печень, кости позвоночника и головной мозг.
Стадии заболевания
Существуют такие этапы развития мелкоклеточного рака легких:
| Стадия | Характеристика |
| 1 | Незначительные размеры новообразования |
| 2 | Блокировка просвета бронха и как результат ателектаз или спадение легочной ткани |
| 3 | Поражение регионарных лимфатических узлов и соседних органов |
| 4 | Появление отдаленных метастазов |
Лечение патологии
Терапия при раке легкого зависит от того, на какой стадии был обнаружен процесс. При ограниченном новообразовании основным методом является операция с удалением доли, сегмента или одного легкого.
Однако рак легких чаще всего определяется, как неоперабельный из-за агрессивного характера роста новообразования. Терапия мелкоклеточного рака заключается в проведении полихимиотерапии с использованием платиноидов.
После метастазирования в отдаленные органы рекомендуется принимать сочетание нескольких средств. Наиболее распространенными среди них являются «Этопозид», «Цисплатин» и «Карбоплатин». Еще используется дистанционная лучевая терапия, что локализуется регионарно.
Облучение является методом паллиативной терапии, помогающим продлить жизнь пациента. Также важно проводит поддерживающую терапию с использованием обезболивающих и противорвотных средств.
Прогноз для жизни
Лечение мелкоклеточного рака легких эффективно только на начальных этапах развития опухоли. При обнаружении ограниченной формы новообразования пятилетняя выживаемость составляет всего 30%.
В случае формирования вторичных очагов продолжительность жизни пациента составляет не более года, в среднем 10 месяцев.
Рецидив рака является неблагоприятным прогностическим критерием и не поддается лечению.

Буква N обозначает поражение различных групп лимфатических узлов. N0 – очагов в лимфоузлах нет, N1–3 – разные степени распространения опухолевых клеток в лимфатические узлы.
Буква M характеризует наличие отдаленных метастазов. M0 – вторичные очаги в других органах не обнаружены, M1 – произошло метастазирование.
Для удобства разные значения T, N и M объединяют в пять стадий, которые обозначают цифрами от 0 до IV. Стадия 0 НМРЛ это «рак на месте», стадия IV – злокачественная опухоль с метастазами.
Стадия немелкоклеточного рака легких – основной фактор, от которого зависит выбор методов лечения и прогноз для пациента.
Немелкоклеточный рак легкого представляет собой группу злокачественных опухолей разных гистологических типов. Наиболее распространена аденокарцинома – опухоль из клеток, вырабатывающих слизь, которая встречается в 40% случаев. Аденокарциномы обычно находятся в периферических частях легкого, отличаются относительно медленным ростом.
Плоскоклеточный рак встречается в 25–30% случаев. Он развивается из плоского эпителия, выстилающего внутреннюю поверхность дыхательных путей. Такие злокачественные опухоли чаще всего находятся в центральной части легкого, вблизи бронхов.
Около 10–15% случаев НМРЛ приходится на недифференцированные крупноклеточные карциномы. Это наиболее агрессивная разновидность, с ней сложно бороться. Такая злокачественная опухоль может находиться в любой части легкого.
Отзывы наших пациентов
- «Медицина 24/7» — единственное место, где смогли помочь9 апреля 2020 г.Наша клиника стала единственным местом, где смогли помочь пациентке. Все остальные от неё отказались из-за возраста и сопутствующих заболеваний. Причиной госпитализации стала угроза перелома первого поясничного позвонка на фоне вторичного поражения. Пациентке провели вертебропластику под КТ-контролем и первый курс иммунотерапии. Впереди дальнейшее лечение.«Единственная клиника, где мы нашли помощь и очень хороших специалистов. Выражаю благодарность докторам…
- Мы найдём выход из сложной ситуации! Отзыв пациента7 апреля 2020 г.Выезд на лечение в зарубежные клиники невозможен. Многие отечественные клиники на карантине. Рак не даёт отсрочку от лечения. Что делать в этой ситуации?Раньше Галина Михайловна лечилась в Израиле. В условиях нынешней ситуации она обратилась к нам для проведения пластики и химиотерапии. Пациентка рада, что «Медицина 24/7» работает в штатном режиме. Галина Михайловна отмечает высокий уровень лечения, сравнимый с зарубежной медициной.«Здесь…
- Удалили опухоль весом 5 кг. Сделали невозможное3 мартa 2020 г.Многие пациенты обращаются в клинику «Медицина 24/7» после того, как другие врачи признали их неизлечимыми. Такой случай перед нами. Перед обращением в клинику пациентка проходила лечение по месту жительства. Диагноз — саркома матки. После проведения операции и курсов химиотерапии болезнь вернулась. В брюшной полости образовалась гигантская опухоль весом свыше 5 кг. Ей отказали в операции из-за многочисленных рисков. Пациентка обратилась…
- Лечение онкологии, благодарность дочери28 января 2020 г.Дочь пациента благодарит лечащего врача, Владлену Александровну. По её словам, несмотря на молодой возраст, это очень внимательный, квалифицированный врач, знающий все новейшие методы лечения и диагностики. Она отмечает качественное обследование. Кроме того, дочь пациента выражает благодарность всему персоналу и заведующему онкологическим отделением, Сергееву Петру Сергеевичу, за лечение её отца.
- «Не отказались, не отправили домой умирать»…24 января 2020 г.К сожалению, бывают случаи, когда больным отказывают в госпитализации из-за тяжести их состояния. Никто не хочет брать ответственность за их жизнь. Подобная ситуация возможна где угодно, но только не в клинике «Медицина 24/7». Бороться за жизнь до последнего, не взирая ни на что — кредо наших врачей. Во многих случаях это удаётся.Перед нами человек, отца которого доставили в клинику «Медицина 24/7» в тяжёлом состоянии. Он был помещён в отделение…
- Благодарность за лечение20 января 2020 г.Пациент благодарит своего лечащего врача за его профессионализма и внимание по отношению к пациентам. По его мнению, он достоин высокого звания врача.Пациент рассказывает: «Мне понравилось то, что персонал ответственный, внимательный, решает мои проблемы очень быстро. На данном этапе те задачи, которые ставились, решены».
- Лечение рака ротоглотки в клинике «Медицина 24/7»20 января 2020 г.Курение — один из факторов появления рака ротоглотки. В последнее время подобный диагноз ставится всё большему количеству людей. Именно с таким заболеванием пациент поступил в клинику «Медицина 24/7». До появления опухоли у него не было никаких жалоб на здоровье. По итогам консилиума ему была определена индивидуальная тактика лечения. На данный момент оно заключается в проведении химиотерапии с комбинированием трёх препаратов. Лечение осуществляется в соответствии…
При выборе методов лечения врач-онколог в первую очередь учитывает стадию НМРЛ, а также его гистологический тип, общее состояние, возраст и сопутствующие заболевания пациента, состояние функции его легких. В последнее время, с появлением современных таргетных препаратов и иммунотерапии, важно учитывать молекулярно-генетические характеристики раковых клеток.
Хирургическое лечение
Удалить хирургическим путем можно опухоль, которая не успела сильно распространиться на другие органы. Если новообразование небольшое и находится в пределах легкого, лечение начинают с операции. При более крупных опухолях сперва проводят курс химиотерапии или лучевой терапии.
Существуют разные варианты операций:
- Пневмэктомия – удаление всего легкого.
- Лобэктомия – удаление доли легкого.
- Сегментарная резекция (сегментэктомия) – удаление сегмента легкого.
- Клиновидная резекция – удаление небольшой части легкого, злокачественной опухоли вместе с участком окружающих здоровых тканей.
Выбирая объем хирургического вмешательства, хирург ориентируется не только на размеры опухоли, но и на функциональное состояние легких пациента. Если дыхательная функция не нарушена, будет удален больший объем тканей, это помогает снизить вероятность рецидива.
Классические операции при немелкоклеточном раке легкого выполняются с помощью торакотомии – через разрез на грудной стенке. Эти вмешательства довольно травматичны и требуют длительного восстановления.
В настоящее время становятся все более популярны видеоторакоскопические резекции легкого (VATS). На грудной стенке делают 2–3 прокола. Через один вводят торакоскоп с видеокамерой, через другие – специальные хирургические инструменты.
Такие операции менее травматичны, после них пациенты быстрее восстанавливаются, ниже риск осложнений.
Химиотерапия при немелкоклеточном раке легкого может преследовать разные цели:
- Неоадъювантная – проводится до операции, помогает уменьшить опухоль и облегчить её удаление, снизить риск рецидива.
- Адъювантная – химиопрепараты вводят после хирургического вмешательства, чтобы уничтожить оставшиеся раковые клетки и предотвратить рецидив.
- В качестве основного метода лечения – в паллиативных целях, при неоперабельном раке легкого, на поздних стадиях.
Применяют сочетания двух химиопрепаратов с разными механизмами действия. Чаще всего в эту схему входят препараты платины – цисплатин, карбоплатин. По данным научных исследований, добавление третьего химиопрепарата не улучшает результаты лечения, но повышает риск серьезных побочных эффектов. Иногда химиотерапию сочетают с таргетной терапией.
Препараты вводят в течение 1–3 дней, затем делают перерыв, необходимый для восстановления организма пациента. Это называется циклом. Один цикл химиотерапии при НМРЛ в среднем продолжается 3–4 недели. Полный курс состоит из 4–6 циклов.
Лучевую терапию также применяют до или после хирургического вмешательства, в качестве основного вида лечения. В ряде случаев её сочетают с введением химиопрепаратов (химиолучевая терапия).
Помимо классического облучения из внешних источников, при раке легких иногда проводят брахитерапию. Источник облучения в виде микроскопических частиц помещают непосредственно в злокачественную опухоль или в дыхательные пути рядом с ней.
Это делают во время операции или бронхоскопии. При брахитерапии излучение распространяется на короткое расстояние и воздействует только на опухоль, минимально затрагивая окружающие здоровые ткани. Спустя некоторое время эти частицы удаляют.
Таргетная терапия, иммунотерапия
Благодаря развитию молекулярной биологии, в настоящее время появились новые классы противоопухолевых препаратов:
- Таргетные препараты воздействуют на конкретную мишень – молекулу, которая нужна опухолевым клеткам, чтобы бесконтрольно размножаться, активировать ангиогенез – образование новых кровеносных сосудов.
- Иммунопрепараты из группы ингибиторов контрольных точек блокируют молекулы, которые сдерживают иммунную систему от атак на опухолевые клетки. Они помогают уничтожить рак путем активации противоопухолевого иммунитета.
Препараты из этих групп зачастую эффективны, когда не работает классическая химиотерапия, они помогают продлевать жизнь пациентов при поздних стадиях НМРЛ.
Но они будут действовать, только если в опухолевой ткани есть соответствующие молекулы-мишени. Для того чтобы их обнаружить, в клинике Медицина 24/7 есть возможность провести молекулярно-генетический анализ.
Это исследование помогает назначить персонализированную терапию, которая будет оптимальна для конкретного пациента.
Главный фактор, определяющий прогноз для пациента – стадия, на которой был диагностирован немелкоклеточный рак. Существуют показатели пятилетней выживаемости – они обозначают процент пациентов, выживших в течение 5 лет после того, как у них был выявлен НМРЛ:
- Если опухоль не успела распространиться за пределы легкого: 60%.
- Если опухоль проросла в соседние органы: 33%.
- Если обнаружены отдаленные метастазы: 6%.
Если диагноз установлен на поздних стадиях, ремиссия, как правило, невозможна. Но врачи в нашей клинике могут назначить паллиативное лечение, которое поможет улучшить состояние больного, замедлить прогрессирование болезни, продлить жизнь. Запишитесь на консультацию к врачу-онкологу по телефону: +7 (495) 230-00-01.
Материал подготовлен заместителем главного врача по лечебной работе клиники «Медицина 24/7», кандидатом медицинских наук Сергеевым Петром Сергеевичем.

По гистологическому происхождению рак легких (РЛ) делят на две основные группы: немелкоклеточный (НМРК) и мелкоклеточный рак (МРЛ). Рак легких немелкоклеточный – это все типы злокачественных карцином отличные от мелкоклеточных.
К группе НМРК относят такие гистологические варианты: аденокарцинома, плоскоклеточный рак, крупноклеточный и смешанные формы. МРЛ имеет своеобразное морфологическое строение и по своим клинико-морфологическим показателям выделен в обособленную единицу.
Болезнь характеризуется большой агрессивностью и быстротой роста опухоли, высокой вероятностью захвата соседних тканей и органов, ее относят к недифференцированному раку.
Также существует ряд терапевтических особенностей, связанных в первую очередь с противопоказаниями к хирургическому методу и с высокой чувствительностью к химиотерапии. В последние годы данной форме рака уделяется все больше внимания, проводятся дополнительные исследования позволяющие поменять подходы к лечению.
Особенности прогрессирования мелкоклеточного рака легких.
Общая характеристика
Мелкоклеточный РЛ.
Мелкоклеточный рак легкого (на фото) из всех гистологических видов легочных карцином имеет наиболее высокую степень агрессивности, характеризуется ранним метастазированием и быстрым обсеменением тканей легкого.
Среди раковых патологий легких занимает достаточно существенную нишу – 20-25% от числа всех заболевших. Основная категория людей, у которых диагностируют мелкоклеточную карциному это курильщики. Именно никотиновый фактор, является основной причиной болезни.
У некурящих фиксируют МРЛ, только в 1% случаев.
Как курение убивает легкие.
Одним из ярких проявлений мелкоклеточного рака является скорость увеличения объема опухоли и большая вероятность лимфогематогенного метастазирования. Средняя скорость удвоения опухоли составляет 33 дня, а для аденокарциномы и плоскоклеточного рака этот показатель составляет 190 и 105 дней соответственно.
Способность к метастазированию во внутригрудные лимфоузлы и отдаленные органы намного выше, чем у других гистологических форм. Неутешительные статистические показатели говорят о том, что у 93% больных выявляются регионарные метастазы.
Частым симптоматическим показателем является появления синдрома сдавления верхней полой вены.
Симптоматике свойственно более раннее и яркое проявление. На момент постановки диагноза у 80% пациентов с мелкоклеточной формой признаки патологии показывали себя на протяжении всего 3 месяцев.
В то же время, для других основных форм рака на начальных стадиях свойственны более скудные клинические показатели, которые до момента выявления болезни манифестируют уже около 8 месяцев.
Для аденокарциномы в 25% случаях фиксируют полное отсутствие клинических маркеров болезни.
Характерная симптоматика часто отсутствует.
Если рассматривать вопрос гистогенеза клеток МРЛ, то существует две теории его происхождения. Первая относит его к нейроэндокринным опухолям, которые образуются из нейроэндокринных клеток объединённых под термином АPUD-системы.
Поэтому, данный вид онкологии встречается под названием мелкоклеточный нейроэндокринный рак легкого.
Связывают это, прежде всего с продуцированием клетками рака биологически активных веществ и появлением типичных нейроэндокринных паранеопластических синдромов.
Нейроэндокринный мелкоклеточный рак легкого не рассматривается как подвид легочной карциномы, и его относят к отдельной нозологической единице.
Сторонники второй теории возникновения утверждают, что злокачественная опухоль образуется из клеток бронхиального эпителия, как и другие виды карцином. Доказательством этого служат схожие гистологические показатели с другими эпителиальными видами рака.
К тому же, мелкоклеточный рак имеет ряд отличий характерных для остальных нейроэндокринных опухолей, в том числе и от карциноида.
Особенности места расположения опухоли
Характерные особенности поражения.
В начале развития МРЛ в 80% случаев имеет крупнобронхиальную локализацию. В дальнейшем, по мере роста опухоль разрастается до периферии легкого, происходит метастазирование в регионарные и отдаленные лимфоузлы, и другие органы организма.
Статистические показатели относительно стороны развития опухолевого процесса не имеют существенной разницы: в 49% случая обнаруживается правостороннее поражение, в 51% — левостороннее. Центральный мелкоклеточный рак левого легкого имеет такую же тенденцию к метастазированию в лимфоузлы, как и рак правого легкого.
Разница лишь в том, что при правосторонней локализации лимфоузлы средостения поражаются чаще, чем бронхопульмональные и корневые – соответственно 51% и 16%. При развитии левостороннего очага разница не существенна – 31 против 41%. Наиболее часто опухоль развивается в верхних долях – 68%.
Если при этом происходит поражение верхнего бронха, то метастазирование в лимфоузлы выявляется в 90% случаев.
Связь локализации образования и процесса терапии.
На решения, принимаемые во время лечения, практически не влияет сторона развития опухолевого процесса. На первый план для онкологов выходит состояние лимфатической системы, и ее патологические изменения.
Классификация
Мелкоклеточный РЛ – прогноз неблагоприятный.
Общепринятая оценка распространенности мелкоклеточного рака сходна со стадированием других типов раковых онкологий легких. Учитывая размер новообразования и степень метастазирования, выделяют 4 стадии по международной системе TNM.
В пульмонологии существует еще одно разделение патологического процесса, показывающее распространенность очага поражения. Выделяют локализованную и распространенную стадию. При локализованной идет одностороннее развитие очага, с поражением регионарных, медиастинальных и надключичных лимфатических узлов.
Распространенная стадия означает переход опухоли на соседнее легкое, появление плеврита и метастазов. Учитывая то, что у большинства пациентов на момент постановки диагноза констатируют III или IV стадию по TNM.
Поэтому, в современной медицине достаточно актуальной остается классификация болезни на локализованную и распространенную форму.
Характерно отсутствие симптомов на 1 и 2 стадии патологического процесса.
На микроскопическом уровне выделяют следующую гистологическую классификацию:
- промежуточный;
- комбинированый;
Овсяноклеточный – опухоль состоит из веретенообразных клеток различной конфигурации, и по размеру в два раза больше лимфоцитов. Ядра округлой или овальной формы, цитоплазма выражено слабо. Незначительный слой цитоплазмы создает впечатление голого ядра. Данный гистологический подтип дает слабую лимфоидную инфильтрацию.
Гистологическое исследование.
Промежуточный – клетки, ядра которых сходны с овсяноклеточными, однако с более четкой структурой и выраженной цитоплазмой. Сами клетки большего размера, имеют продолговатую форму или округлые очертания.
Комбинированный – наиболее редко встречающаяся морфологическая форма МРЛ. Об этом подвиде свидетельствует сочетание признаков овсяноклеточного с аденокарциномой или плоскоклеточным раком.
Существование различных морфологических вариаций у одной из самых агрессивных форм рака, практически не влияет на методику лечения. Любой подтип МРЛ бурно развивается и имеет большой потенциал в метастазировании. Поэтому в онкологической практике при выборе терапевтической тактики не учитывают микроскопические подтипы мелкоклеточной формы рака.
Диагностика
Компьютерная томография.
Инструментальная диагностика после сбора и анализа клинических показателей будет заключаться в визуализации опухолевого процесса и определение распространенности процесса. Достигается это с помощью следующих методик:
- рентгенография;
- компьютерная томографии (КТ);
- морфологическая диагностика;
- МРТ головного мозга;
- сканирование костей;
- позитронно-эмиссионная томография (ПЭТ-КТ);
На рентгенограмме первичная опухоль отображается в виде патологического затемнения, совместно с увеличившимися с лимфатическими узлами. Наиболее эффективным неинвазивным способом выявления метастазов в лимфоузлах является КТ. Поэтому томография обязательный диагностический метод перед определением тактики лечения.
Рентгенография как основной метод исследования.
Сталкиваются с определенными сложностями при дифференциальной диагностике некоторых видов немелкоклеточного низкодифференцированного рака, карциноидами или воспалениями. Морфологические анализы берутся с помощью бронхоскопии с биопсией, трансторакальной пункции и биопсии метастатических узлов. Именно микроскопический анализ клеток выдает точную гистологическую характеристику рака.
После морфологического заверения диагноза, проводят обследования для определения метастазирования в другие органы и кости скелета. Для этого проводят МРТ и сканирование костей. ПЭТ-КТ позволяет получить более достоверные данные о стадии болезни, о состоянии органов и тканей. Данный метод позволяет выявить первичный узел при уже обнаруженных метастазах.
Лечение и прогноз
Как проходит лечение.
Интенсивность злокачественного процесса и раннее метастазирование при МРЛ предопределяет вид лечения и ухудшение прогноза. В классическом понимании терапевтическая инструкция по лечению мелкоклеточного рака заключается в применении химиотерапии и лучевой терапии.
Связано это прежде всего с общеизвестными противопоказаниями к применению хирургического лечения. Однако в последние десятилетия медицина стала ломать шаблонные представления о лечении МРЛ, и все чаще стали применяться новые высокоэффективные подходы в излечении агрессивной онкопатологии.
Оперативное вмешательство.
Наиболее приемлемый результат достигается при проведении хирургического вмешательства. Подобный сценарий вступает в действие на I и II стадиях, с локализованной формой и без регионарных метастазов.
К сожалению, данный благоприятный вариант используется относительно нечасто, ввиду того, что основным ограничителем радикального метода выступает факт обнаружения у 80-90% больных достаточно развитого опухолевого процесса. В то же время, лечение мелкоклеточного рака легких с помощью хирургии, должно сочетаться с курсами послеоперационной полихимиотерапии.
Проводимые исследования доказали преимущество оперативного вмешательства перед проведением, только лучевого облучения. Сочетание хирургии и химиотерапии позволяет перешагнуть порог пятилетней выживаемости 40% заболевшим.
Важно! Даже на первых стадиях для операбельных больных проведение химиотерапии является обязательным.
Химиотерапия как обязательный этап лечения.
На поздних стадиях хорошо зарекомендовало себя использование комбинированной химиотерапии и облучения. С распространенным МРЛ облучение (видео в этой статье) проводится по терапевтическим показаниям.
Основным показателем к применению лучевой терапии является метастазирование в головной мозг и надпочечники. Химиопрепараты наиболее действенны при поражении метастазами регионарных лимфоузлов и плевры.
Комбинация двух методик показана при метастазах в узлах средостения.
Результаты терапия редко бывают утешительными.
Хорошая чувствительность МРЛ к химии и облучению давно доказана, но в то же время, говорить о хороших показателях не приходиться. В большинстве случаев наступает рецидив.
Цена повторного наступления болезни неутешительна, больные в этом случае подпадают в категорию неизлечимых. При сравнении прогноза с локализованной и распространенной формой, то первый вариант имеет достоверно лучшие показатели.
Такие критерии, как возраст или подтип МРЛ практически не учитываются.
Таблица прогноза выживаемости
СтадияВид леченияПятилетняя выживаемость в %1Хирургический с курсами полихимиотерапии 402 —— 28-353-4Химиотерапия и облучение 5-15
Таким образом, МРЛ имеет сложности не только в дифференциальной диагностике, но и в лечении этой одной из самых тяжелых онкологических болезней. Врач, принимая пациентов с подобным диагнозом, стоит перед множеством неразрешимых дилемм.
Этот вид рака содержит в себе все основные трудности, с которыми сталкивается современная онкология.
Поэтому, для достижения максимально положительного результата необходимо прибегать к использованию всех доступных диагностических и лечебных мероприятий.
Читать далее…
Рак – злокачественное новообразование, уничтожающее здоровые клетки организма в результате мутации. По данным международного агентства по изучению рака, самая распространённая его локация – лёгкие.
По своей морфологии рак лёгкого подразделяется на немелкоклеточный (в том числе аденокарцинома, плоскоклеточный, крупноклеточный, смешанный) — порядка 80-85% от всей заболеваемости, и мелкоклеточный – 15-20%. В настоящее время существует теория развития мелкоклеточного рака легкого в результате перерождения клеток эпителиальной выстилки бронхов.
Мелкоклеточный рак лёгкого – наиболее агрессивный, характеризуется ранним метастазированием, скрытым течением и самыми неблагоприятными прогнозами, даже в случае лечения. Мелкоклеточный рак лёгких — самый трудноизлечимый, в 85% случаях заканчивается летально.
Ранние стадии протекают бессимптомно и чаще определяются случайно при профилактических осмотрах или обращении в поликлинику с другими проблемами.
Симптомы могут указать на необходимость обследования. Появление же симптомов в случае МРЛ может говорить об уже продвинутой стадии рака лёгкого.
Симптомы рака лёгкого
- Кашель;
- Одышка;
- Шумное дыхание;
- Деформация пальцев «барабанные палочки»;
- Дерматит;
- Кровохарканье;
- Похудание;
- Симптомы общей интоксикации;
- Температура;
- В 4-ой стадии — обструктивная пневмония, появляются вторичные признаки со стороны поражённых органов: боли в костях, головные боли, путаное сознание.
Признаки патологии могут отличаться в зависимости от нахождения первоначального новообразования.
Мелкоклеточный рак чаще бывает центральным, реже — периферийным. Причём первичная опухоль рентгенографически выявляется крайне редко.
Стадии МРЛ
- Новообразование размером менее 3 см (измеряется в направлении максимальной вытянутости), располагается в одном сегменте.
- Менее 6 см, не выходящая за пределы одного сегмента лёгкого (бронха), единичные метастазы в близлежащих лимфоузлах
- Более 6 см, затрагивает ближние доли лёгкого, соседний бронх, или выходом в главный бронх. Метастазы распространяются на дальние лимфоузлы.
- Раковая неоплазияможет выйти за пределы лёгкого, с произрастанием в соседние органы, множественное отдалённое метастазирование.
Международная классификация TNM
Где Т- показатель состояния первичной опухоли, N – регионарных лимфоузлов, М – отдалённого метастазирования
Tx – данные недостаточны для оценки состояния опухоли, либо она не выявлена,
T0 – опухоль не определяется,
TIS – неинвазивный рак
и от T1 до T4 – стадии роста опухоли от: менее 3 см, до величины, когда размеры не имеет значения; и стадии расположения: от локального в одной доле, до захвата лёгочной артерии, средостенья, сердце, карины, т.е. до произрастания в соседние органы.
N – показатель состояния регионарных лимфоузлов:
Nх – данные недостаточны для оценивания их состояния,
N0 – метастазическое поражение не выявлено,
N1 – N3 — характеризуют степень поражения: от ближних лимфоузлов, до расположенных на стороне, противоположной опухоли.
М – состояние отдалённого метастазирования:
Mх – недостаточно данных для определения отдалённых метастазов,
M0 – отдалённых метастазов не обнаружено,
M1 – M3 – динамика: от присутствия признаков единичного метастазирования, до выхода за пределы грудной полости.
Более 2/3 пациентов ставится III-IV стадия, поэтому МРЛ продолжают рассматривать по критериям двух значимых категорий: локализованный или распространённый.
Лечение
В случае постановки этого диагноза лечение мелкоклеточного рака лёгких напрямую зависит от степени поражения органов конкретного пациента с учётом его анамнеза.
Химиотерапия в онкологии используется для формирования границ опухоли (перед её удалением), в послеоперационный период для уничтожения возможных раковых клеток и как основная часть лечебного процесса. Она должна уменьшить опухоль, лучевая терапия – закрепить результат.
Лучевая терапия – ионизирующая радиация, которая убивает раковые клетки. Современные приборы генерируют узконаправленные лучи, минимально травмирующие находящиеся рядом области здоровых тканей.
Необходимость и последовательность хирургических методов и терапевтических определяется непосредственно лечащим врачом-онкологом. Цель терапии — достигнуть ремиссии, желательно полной.
Лечебные процедуры — ранние стадии
Хирургическое оперативное вмешательство — к сожалению, единственная возможность на сегодняшний день для удаления раковых клеток. Метод используется на I и II стадиях: удаление целиком лёгкого, доли или его части.
Послеоперационная химиотерапия — обязательный компонент лечения, как правило, с лучевой терапией. В отличие от немелкоклеточного рака легкого, в начальной стадии которого возможно ограничиться удалением опухоли/.
Даже в этом случае 5-ти летняя выживаемость не превышает 40%.
Схему химиотерапии выписывает онколог (химиотерапевт) — лекарственные препараты, их дозировки, длительность и их количество. Оценивая их эффективность и исходя из самочувствия пациента, врач может корректировать курс лечения.
Как правило, дополнительно выписываются противорвотные препараты. Различные альтернативные способы лечения, БАДы, в том числе и витамины, могут ухудшить ваше состояние.
Необходимо обсудить их приём с онкологом, как и любые значимые изменения в вашем здоровье.
Лечебные процедуры — 3,4 стадии
Обычная схема при локализованных формах более сложных случаев — комбинированная терапия: полихимиотерапия (поли- означает использование не одного, а комбинации препаратов) — 2-4 курса, целесообразно в сочетании с лучевой терапией на первичную опухоль. При достижении ремиссии возможно профилактическое облучение головного мозга. Такая терапия увеличивает продолжительность жизни в среднем до 2-х лет.
При распространённой форме: полихимиотерапия 4-6 курсов, лучевая терапия — по показаниям.
В случаях, когда рост опухоли остановился, говорится о частичной ремиссии.
Мелкоклеточный рак легкого очень хорошо реагирует на химио-, радио- и лучевую терапии. Коварство этой онкологии — велика вероятность рецидивов, которые уже нечувствительны к подобным противоопухолевым процедурам. Возможное течение рецидива — 3-4 месяца.
Метастазирование происходит (раковые клетки переносятся с током крови) в органы, которые наиболее интенсивно снабжаются кровью. Страдают головной мозг, печень, почки, надпочечники. Метастазы проникают в кости, что в том числе приводит к патологическим переломам и инвалидизации.
При неэффективности или невозможности применения вышеперечисленных методов лечения (в силу возрастных и индивидуальных особенностей пациента) проводится паллиативное лечение. Оно направлено на улучшения качества жизни, в основном — симптоматическое, в том числе — обезболивание.
Сколько живут с МРЛ
Длительность жизни напрямую зависит от стадии заболевания, вашего общего состояния здоровья и применяемых методов лечения. По некоторым данным, у женщин чувствительность к лечению лучше.
Скоротечное заболевание может дать вам от 8 до 16 недель, в случае нечувствительности к терапии или отказа от неё.
Употребляемые методы лечения далеки от совершенства, но оно увеличивает ваши шансы.
В случае комбинированного лечения в I и II стадии вероятность 5-ти летней выживаемости (после пяти лет говорится о полной ремиссии) составляет 40%.
На более серьёзных стадиях — продолжительность жизни при комбинированной терапии увеличивается в среднем на 2 года.
У пациентов с локализованной опухолью (т.е. не ранняя стадия, но без далёкого метастазирования) с использованием комплексной терапии 2-х летняя выживаемость — 65-75%, 5-ти летняя выживаемость возможна в 5-10%, при хорошем состоянии здоровья — до 25%.
В случае распространённого МРЛ — 4 стадии, выживаемость до года. Прогноз же полного излечения в таком случае: случаи без рецидивов крайне редки.
Послесловие
Кто-то будет искать причины рака, не понимая, за что ему это.
Легче переносят болезнь люди верующие, воспринимая её как кару или испытание. Возможно, от этого им легче, и пусть это принесёт успокоение и силу духа в борьбе за жизнь.
Позитивный настрой необходим для благоприятного исхода лечения. Только как найти в себе силы противостоять боли и остаться собой. Невозможно дать верный совет человеку, услышавшему страшный диагноз, как и понять его. Хорошо, если вам окажут помощь родные и близкие люди.
Самое важное — найти веру в свои силы, захотеть идти дальше в своё будущее и поверить врачам. Дайте себе шанс.
Загрузка…








